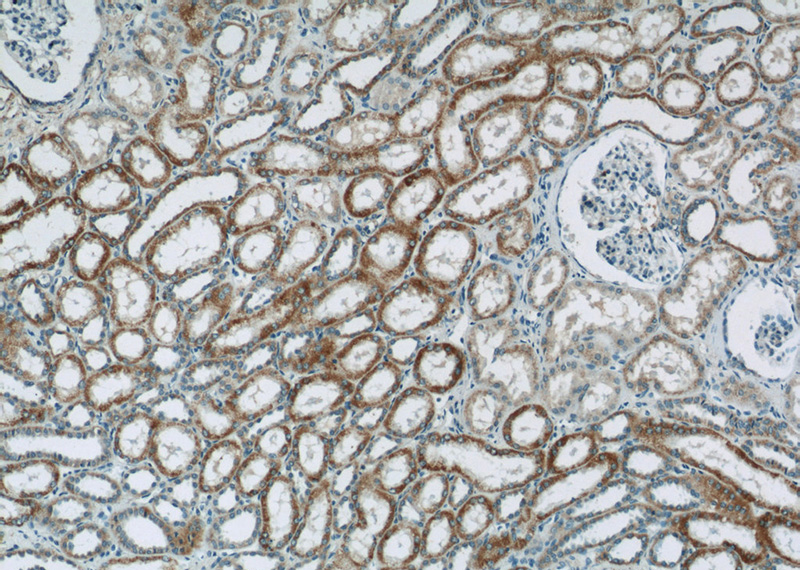
Immunohistochemistry of paraffin-embedded human kidney tissue slide using Catalog No:113088(NDUFV3 Antibody) at dilution of 1:50 (under 10x lens)
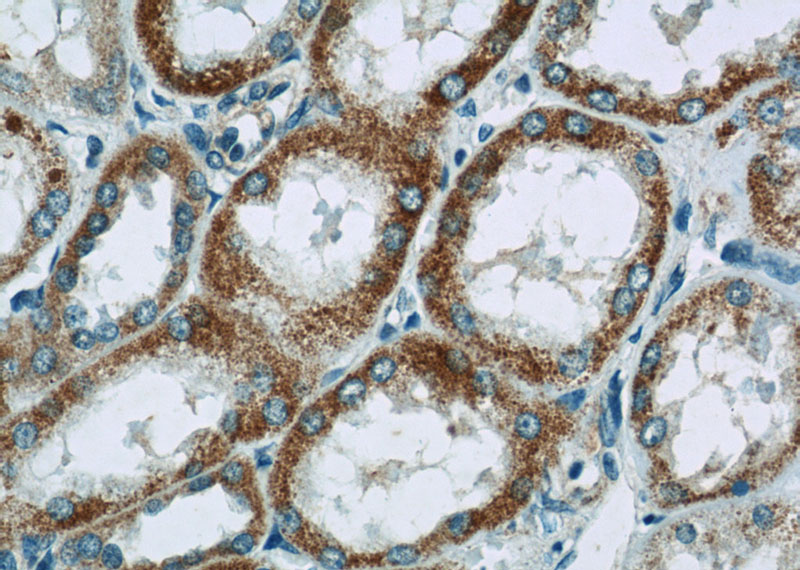
Immunohistochemistry of paraffin-embedded human kidney tissue slide using Catalog No:113088(NDUFV3 Antibody) at dilution of 1:50 (under 40x lens)

-
Product Name
NDUFV3 antibody
- Documents
-
Description
NDUFV3 Rabbit Polyclonal antibody. Positive WB detected in HepG2 cells, human heart tissue, human liver tissue. Positive IHC detected in human kidney tissue. Observed molecular weight by Western-blot: 10kd
-
Tested applications
ELISA, WB, IHC
-
Species reactivity
Human; other species not tested.
-
Alternative names
CI 9KD antibody; Complex I 9kD antibody; NDUFV3 antibody
-
Isotype
Rabbit IgG
-
Preparation
This antibody was obtained by immunization of NDUFV3 recombinant protein (Accession Number: NM_001001503). Purification method: Antigen affinity purified.
-
Clonality
Polyclonal
-
Formulation
PBS with 0.02% sodium azide and 50% glycerol pH 7.3.
-
Storage instructions
Store at -20℃. DO NOT ALIQUOT
-
Applications
Recommended Dilution:
WB: 1:500-1:5000
IHC: 1:20-1:200
-
Validations

HepG2 cells were subjected to SDS PAGE followed by western blot with Catalog No:113088(NDUFV3 antibody) at dilution of 1:300
Immunohistochemistry of paraffin-embedded human kidney tissue slide using Catalog No:113088(NDUFV3 Antibody) at dilution of 1:50 (under 10x lens)
Immunohistochemistry of paraffin-embedded human kidney tissue slide using Catalog No:113088(NDUFV3 Antibody) at dilution of 1:50 (under 40x lens)
-
Background
NDUFV3(NADH dehydrogenase [ubiquinone] flavoprotein 3, mitochondrial) is also named as CI-9kD,Renal carcinoma antigen NY-REN-4 and belongs to the complex I NDUFV3 subunit family.It is an accessory subunit of the mitochondrial membrane respiratory chain NADH dehydrogenase (Complex I), that is believed not to be involved in catalysis.
-
References
- Villeneuve L, Tiede LM, Morsey B, Fox HS. Quantitative proteomics reveals oxygen-dependent changes in neuronal mitochondria affecting function and sensitivity to rotenone. Journal of proteome research. 12(10):4599-606. 2013.
Related Products / Services
Please note: All products are "FOR RESEARCH USE ONLY AND ARE NOT INTENDED FOR DIAGNOSTIC OR THERAPEUTIC USE"
